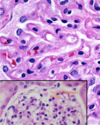

Urology Flashcards
(50 cards)

uremic gastritis
ulcers

uremic gastritis
mineralization

ulcer on tongue d/t uremia

renal hypoplasia
Is this a problem?

incidental
does not affect fxn
horseshoe kidney

solitary renal cyst

multiple renal cysts

PKD

Acute renal infarct

Acute renal infarct after 2-3d

infarct of an entire kidney

large renal infarct

papillary necrosis

papillary necrosis

hydronephrosis

hydronephrosis/hydroureter
What occurred to this kidney?

chronic hydronephrosis
pressure atrophy

GN
thickened basement membranes are observed & increase # mesangial cells
GN
What is observed here d/t GN
incr. # mesangial cells
synechiae= adhesions betw/ glomerular tuft & the capsule

Glomerular sclerosis

Glomerular amyloidosis
Lugol’s iodine stain on fresh tissue (congo red for histo)

glomerular amyloidosis
DDX?
STain used?

glomerular amyloidosis
congo red- fluoresce green with UV light































